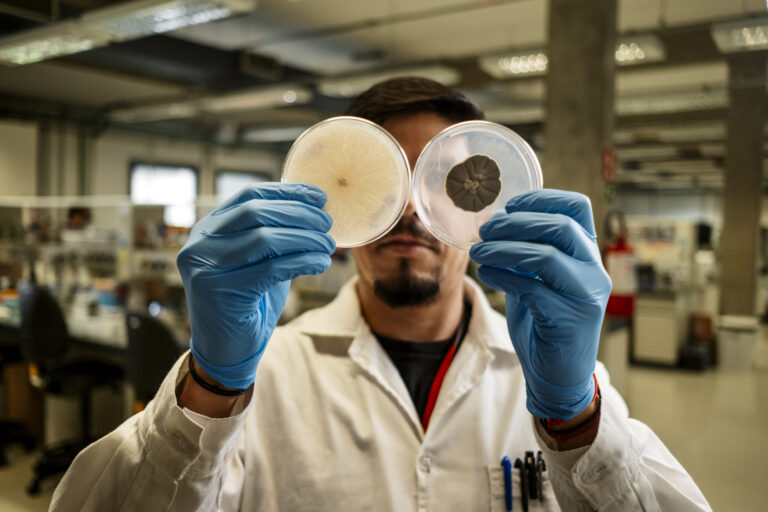

FEATURED STORY
Changing the current model for the catalytic mechanism of enzymes
Published in Nature Communications, the research opens new paths for rational enzyme design and suggests that other molecules could act in a similar way
FEATURED STORY
A new enzyme to boost cellulosic ethanol
Decarbonization is critical. Synthetic biology was used to develop a microbial platform for cellulase production to reduce production costs of cellulosic ethanol
Press releases
PRESS INQUIRIES
LNBR Communications
Erik N. Medina
+55 19 3512-3138
erik.medina@cnpem.br
TRAINING & EVENTS
Training Opportunities
Bioreactors Operation
Biomass Characterization
Events
Workshops & Conferences